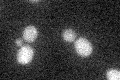
YGR003W
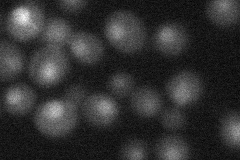
YGR003W
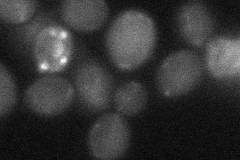
YGR003W

View description
Ubiquitin-protein ligase, member of the cullin family with similarity to Cdc53p and human CUL3; required for ubiquitin-dependent degredation of the RNA Polymerase II subunit RPO21
Localization:
Intensity:
Fold change:
Significance:
-
C’ GFP library in SD
below threshold18.38 -
N' NOP1pr-GFP in SD

cytosol,nucleus44.068 -
N' TEF2pr-mCherry in SD
nucleus15.3793 -
N' NATIVEpr-GFP in SD

below threshold16.963 -
N' TEF2pr-VC and Cyto-VN in SD
below threshold27.1061 -
C’ GFP library in SD+DTT

cytosol16.910.91No -
C’ GFP library in SD+H2O2

cytosol17.230.93No -
C’ GFP library in Starvation Media

cytosol15.360.83No -
C’ GFP library on the background of Pup2-DaMP

below threshold -
C’ GFP library on the background of CCT mutant

below threshold19.46071.05794No
